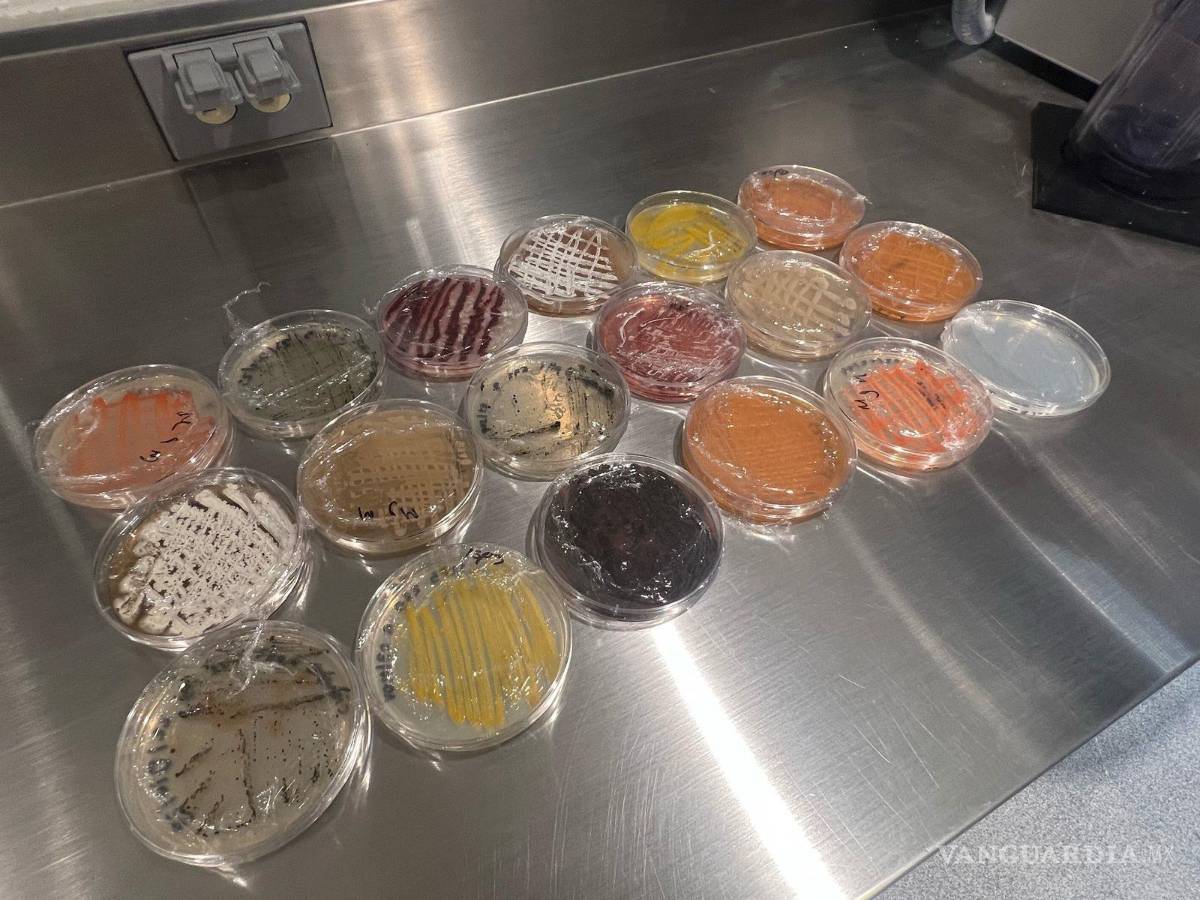
$!De avanzar las investigaciones, se estaría generando antibióticos completamente modernos para el planeta.

Cuatro Ciénegas: científicos investigan microorganismos para crear súper antibióticos y combatir enfermedades que hoy son incurables

COMPARTIR
El científico Héctor Arocha Garza, director del Laboratorio Génesis, informó que desde hace diez años se investiga con éxito la zona para detectar microorganismos que ayuden a generar medicamento antitumoral y superantibióticos.
Los investigadores encontraron en las fosas de Cuatro Ciénegas microorganismos y bacterias que, a nivel laboratorio, lograron matar bacterias que enferman al ser humano en la piel, en el tracto digestivo, en el tracto intestinal, y en diferentes partes del cuerpo como el tracto respiratorio. Actualmente, no hay cómo tratar estas enfermedades.
TE PUEDE INTERESAR: Automedicarse genera resistencia a los antibióticos: Secretaría de Salud Coahuila
La idea nació ante la creciente resistencia a los antibióticos. “Las bacterias que nos enferman a los seres humanos se están haciendo resistentes a los antibióticos que los doctores nos recetan, por el mal uso de estos medicamentos. Entonces a nivel mundial ha crecido una necesidad de buscar nuevos antibióticos para combatir enfermedades que no tienen cura o que se hicieron resistentes”, comentó en entrevista.
Como Cuatro Ciénegas es un lugar único en el mundo, por tener microorganismos endémicos se iniciaron investigaciones desde hace una década. El equipo está integrado por colaboradores del Laboratorio Génesis, en conjunto con la Universidad Autónoma de Nuevo León y el Instituto de Biotecnología.

De acuerdo a la Organización Mundial de la Salud (OMS), la resistencia a los antibióticos ya existentes representa un problema de salud pública.
Por ello, el trabajo de investigación que se realiza en Cuatro Ciénegas podría dar un respiro a la OMS que ha alertado que bacterias, virus, hongos y parásitos han dejado de responder a los antibióticos, lo que incrementa la propagación de las enfermedades y puede llevar a la muerte.
“Estamos muy contentos porque vamos en una etapa avanzada. Aún nos faltan diez más aproximadamente, pero es la primera vez que se encuentra este tipo de sustancias que tienen actividad contra estas enfermedades, que ya eran resistentes”, dijo.
Continuó: “Estamos haciendo un parteaguas en México, porque por primera vez estaremos desarrollando antibióticos totalmente nuevos que ayudarían a la humanidad, no sólo a México, sino a la humanidad”.
UN LUGAR DE INTERÉS INTERNACIONAL
El investigador explicó que Cuatro Ciénegas es un lugar único en el mundo, es un valle que quedó aislado del resto del planeta Tierra hace más de 35 millones de años y tiene seres endémicos, que no existen en ninguna otra parte de nuestro planeta.
TE PUEDE INTERESAR: ‘Presumen’ sobreexplotación de agua en Cuatro Ciénegas; Municipio exige a Conagua monitorear extracción
Además de plantas y animales también existen microorganismos actualmente de hecho todos o la mayoría, aproximadamente el 75% de los antibióticos que utilizamos son producidos por bacterias.

Actualmente, continúan las pruebas en laboratorio. La ruta a seguir es continuar con las pruebas en laboratorio para crear antibióticos.
“Hay que sacarlo y después probarlo en animales y tras ello en humanos... vamos bien, vamos a la mitad del desarrollo, pero con grandes resultados”, dijo.
TE PUEDE INTERESAR: ‘Decidí hacer algo drástico, despedirme de Cuatro Ciénegas... no quiero ser testigo de la muerte de más tortugas y peces’, dice Valeria Souza, investigadora
Conforme avancen las investigaciones y se llegue a las fases finales, se planea involucrar instancias internacionales, así como investigadores de Estados Unidos.








